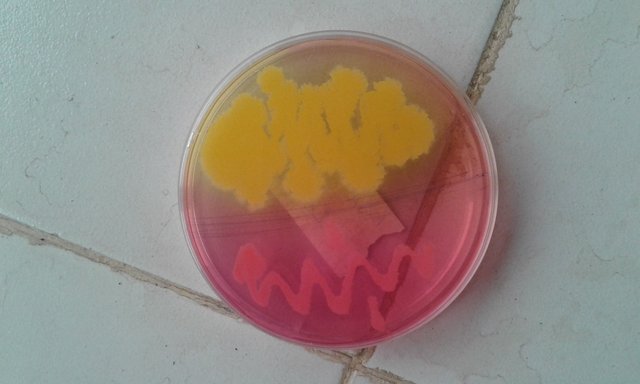
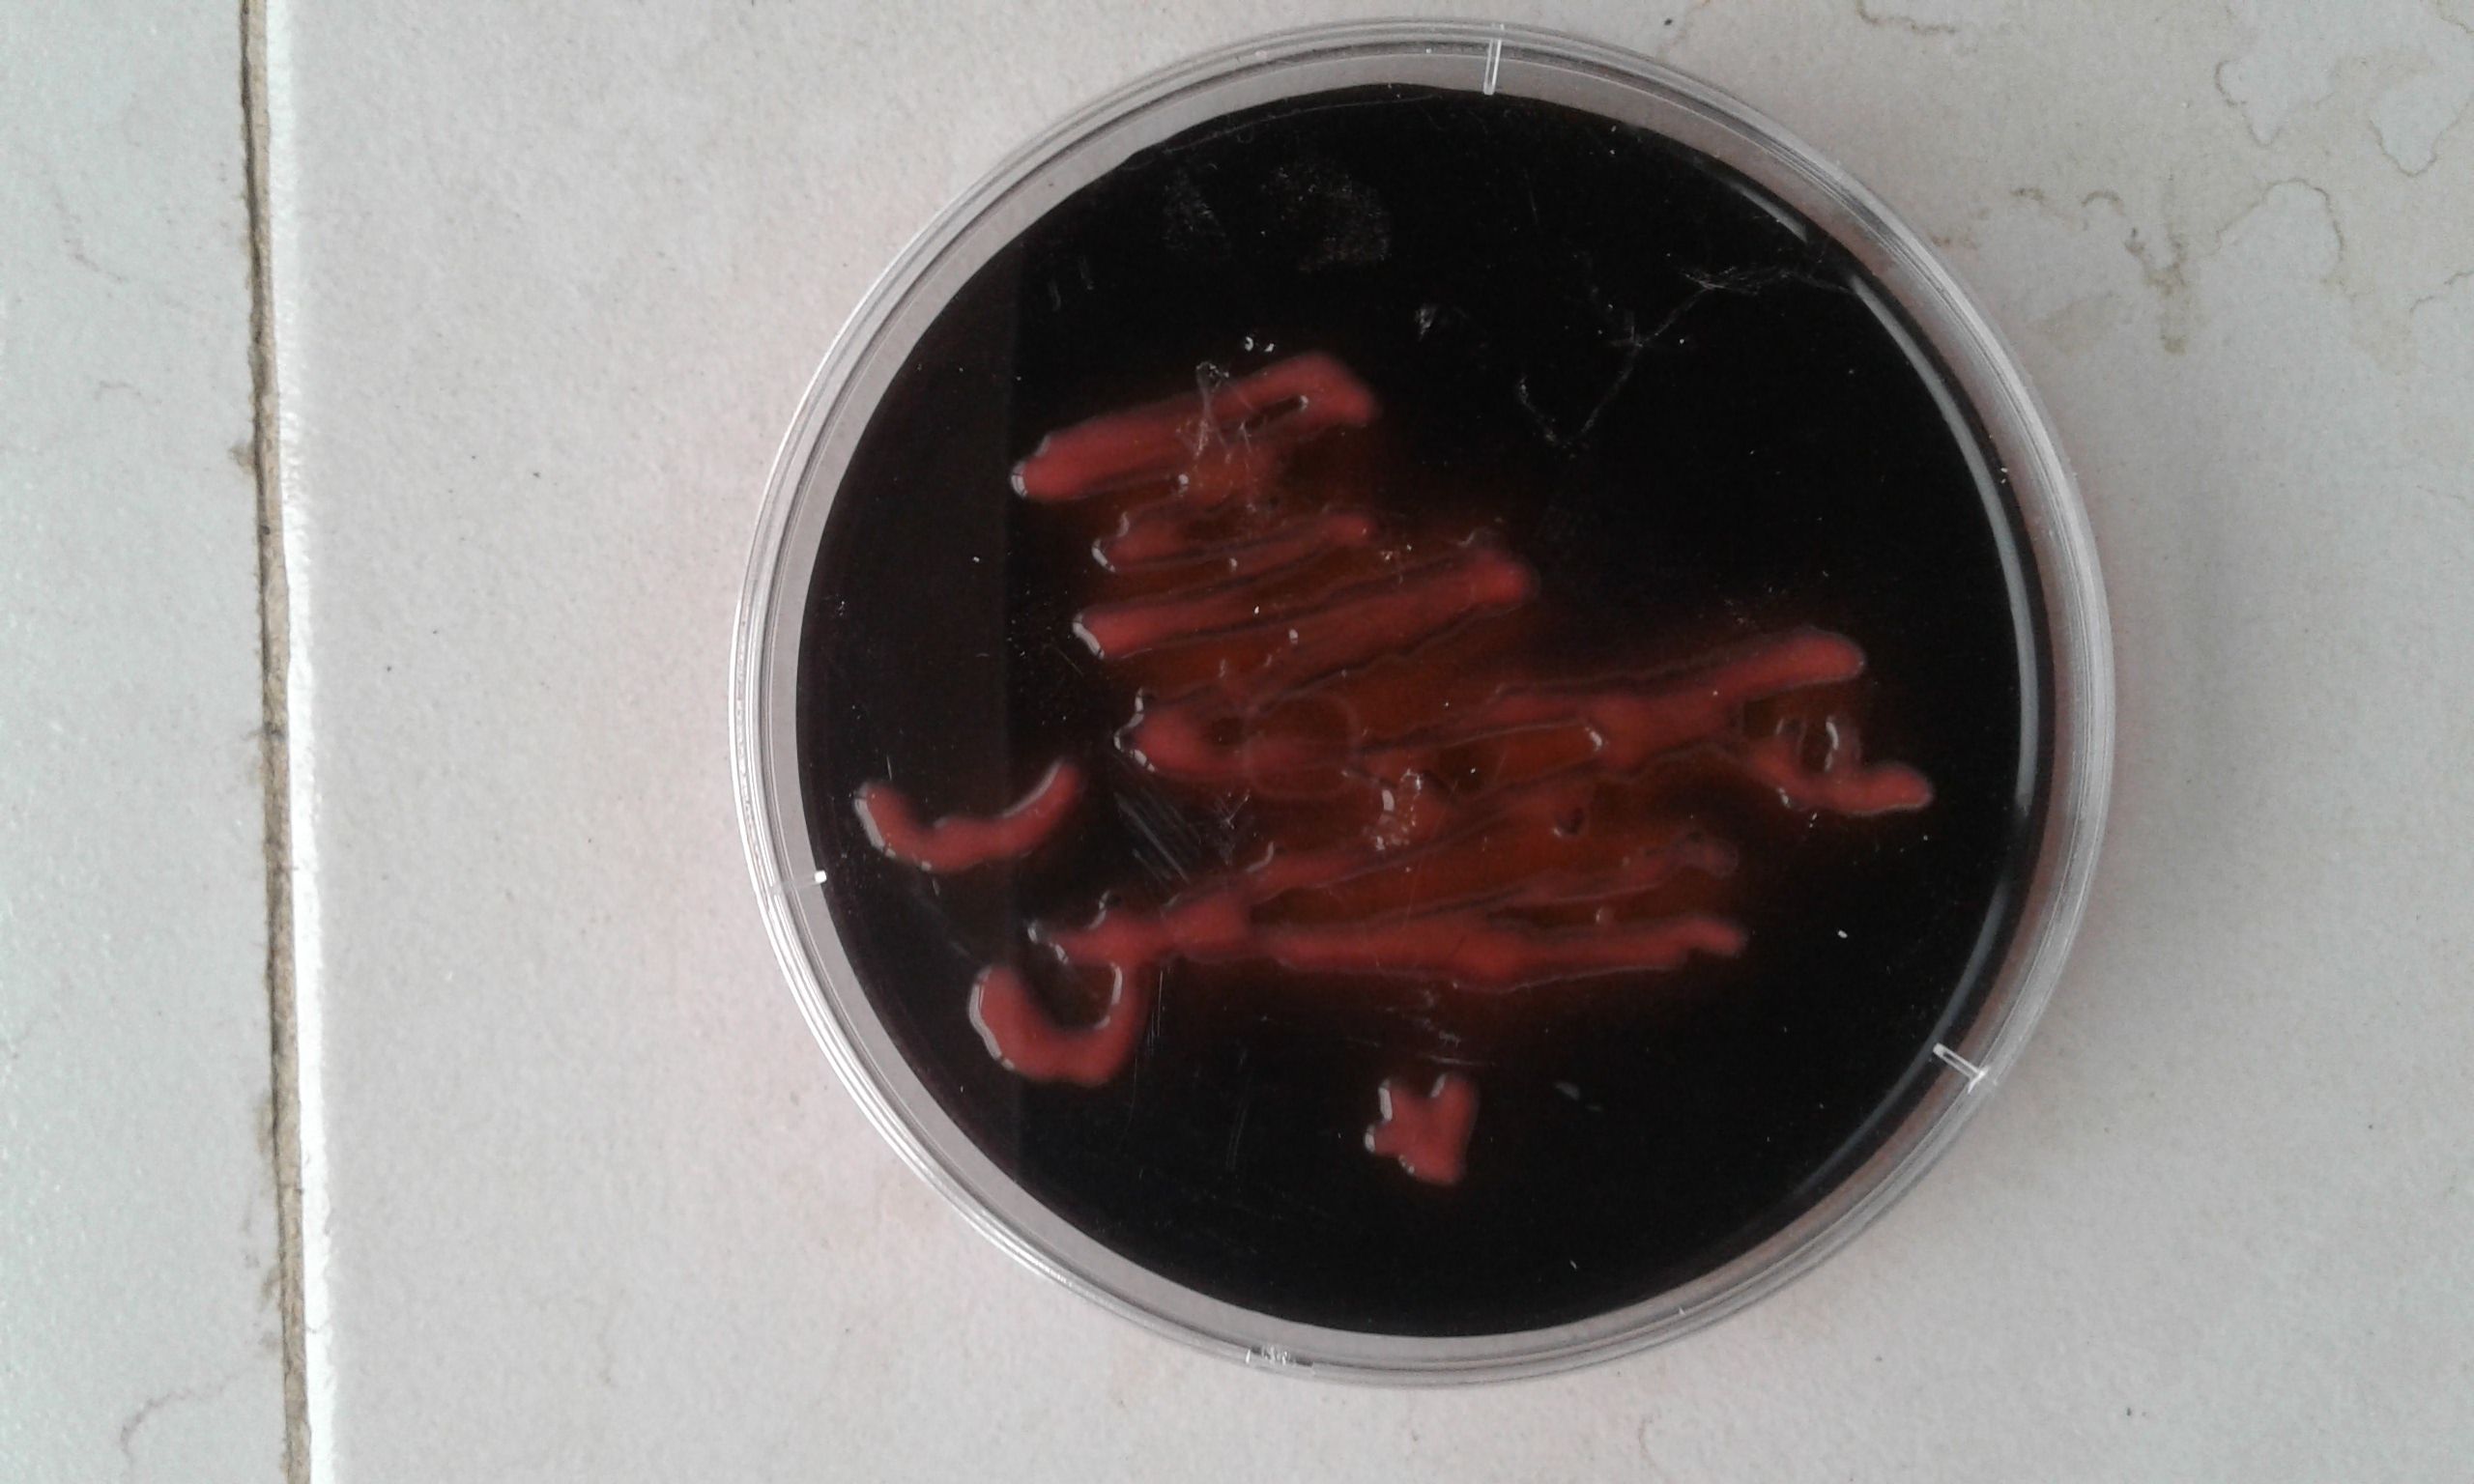
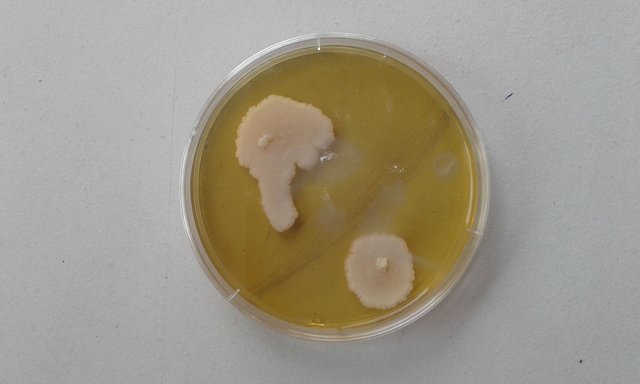
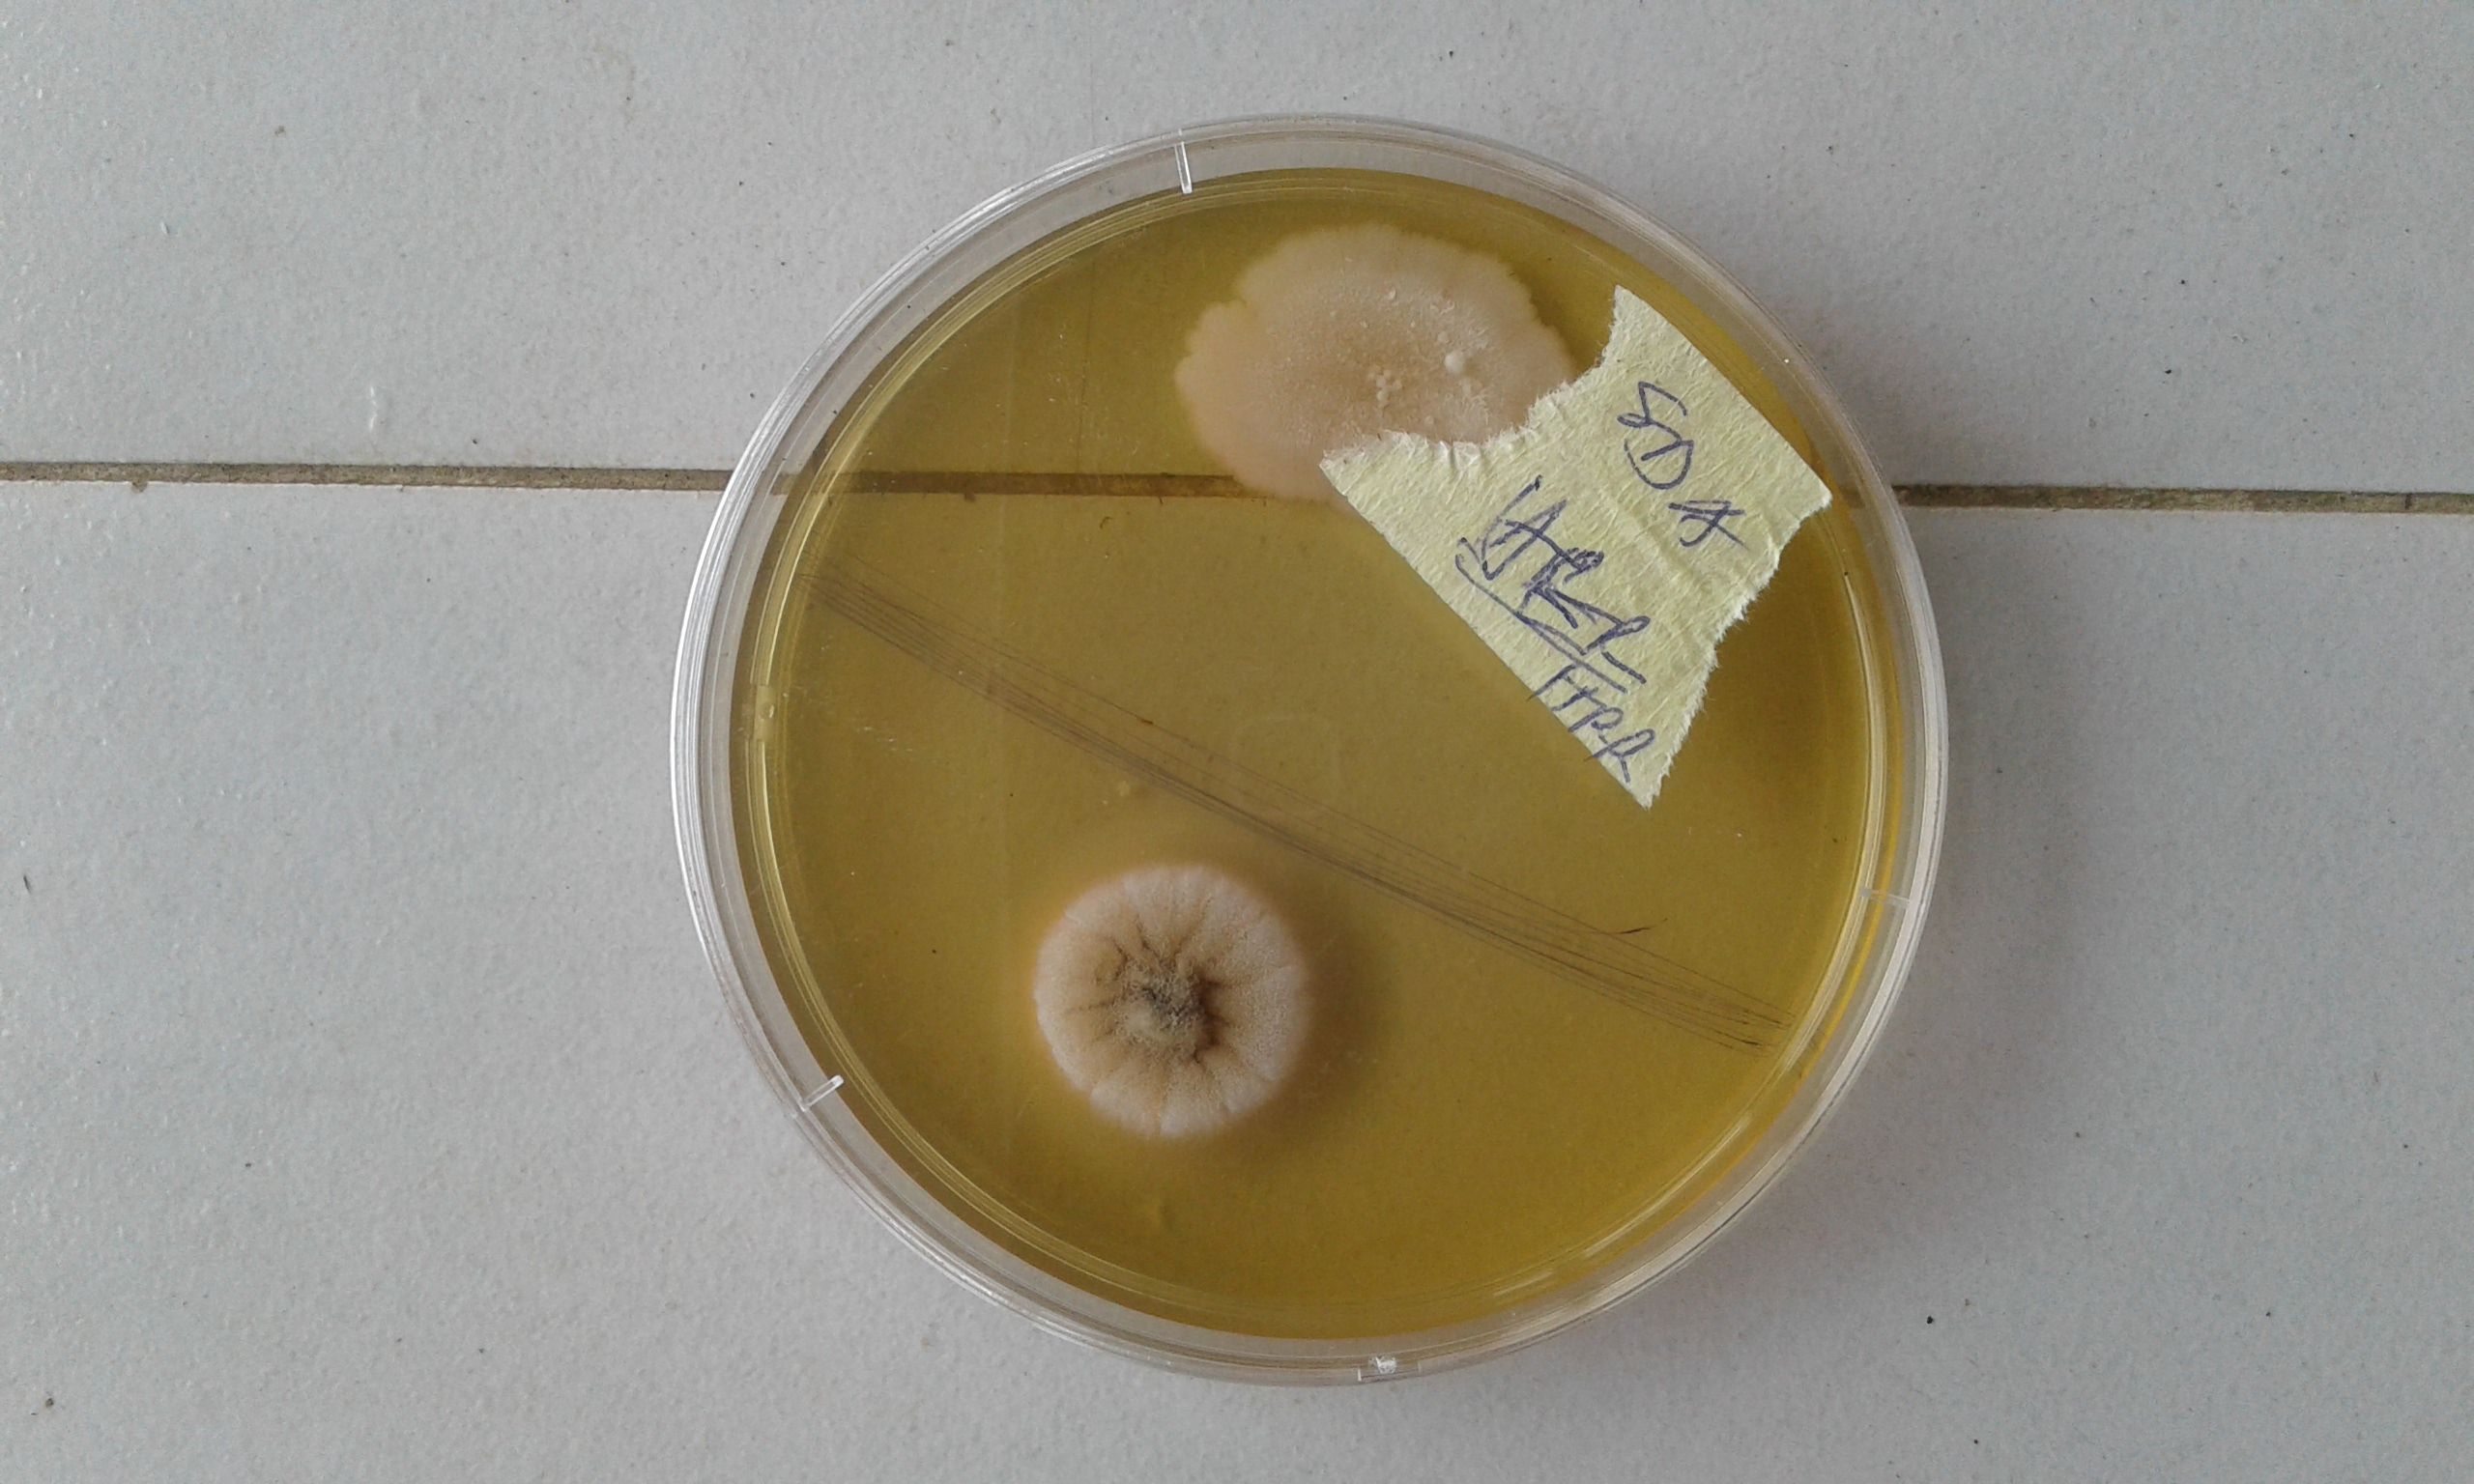
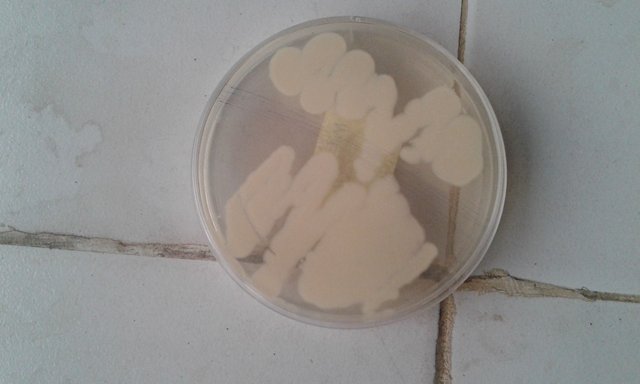

The beauty of microorganisms on Plates
I was in the Laboratory today to check my plates ( i.e isolated microorgansms), the microbes physical distinction (colour, shape, elevation, edge, size) made me glad because it has eased me of the stress of other identification methods. All i need to do now is just to narrow it down for molecular identification.
Check out the beauty of the microbial world
Mannitol fermenting bacteria such as Stapyloccocus aureus
Gram negative bacteria such as Salmonella and Shigella

Hello! I find your post valuable for the wafrica community! Thanks for the great post! @wafrica is now following you! ALWAYs follow @wafrica and use the wafrica tag!
Thanks
Has this been taken from a microscope?
No,this was just the pure isolates after subculturing.
Thanks for the upvote
Your Welcome.